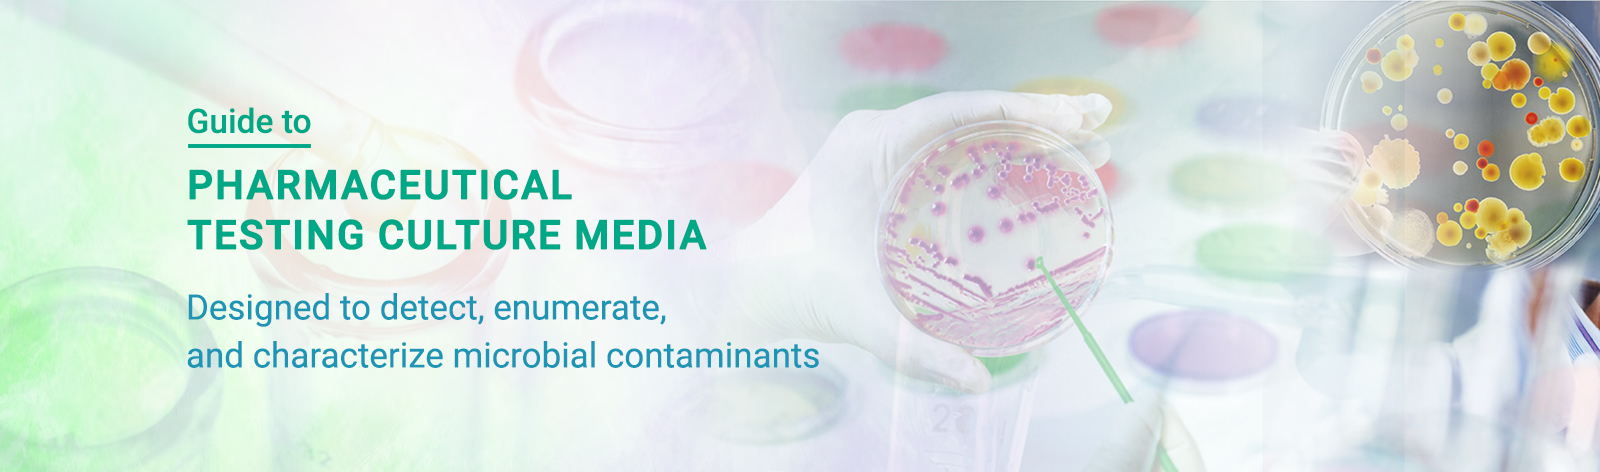

Guide to Pharmaceutical Testing Culture Media
Microbiological testing constitutes a critical element of pharmaceutical quality control systems and plays a fundamental role in ensuring that drug products meet established safety, quality, and regulatory requirements prior to their market release. These tests are designed to detect, enumerate, and characterize microbial contaminants that may arise from raw materials, manufacturing processes, environmental exposure, or inadequate control strategies. At the core of all microbiological testing methodologies lies the use of culture media, which functions as controlled analytical systems that support the recovery and growth of microorganisms under defined laboratory conditions.
In pharmaceutical laboratories, culture media must be regarded as critical analytical reagents rather than routine consumables. The physicochemical properties, nutrient composition, manufacturing consistency, and performance characteristics of culture media have a direct and measurable impact on microbial recovery, detection sensitivity, and reproducibility of results. Deficiencies in culture media formulation or performance may result in false negative outcomes due to inadequate microbial recovery or false positive results arising from contamination or nonspecific growth. Such outcomes can compromise product quality decisions, undermine data integrity, and lead to regulatory noncompliance.
Pharmaceutical testing culture media are used across a broad range of regulated applications, including microbial limits testing, tests for specified microorganisms, sterility testing, antibiotic/vitamin assay methods, environmental monitoring programs, pharmaceutical water testing, and in-process microbiological controls. Given the regulatory significance of these tests, culture media must be scientifically justified for their intended use, performance qualified under laboratory-specific conditions, and fully traceable through documented quality systems.
2. Scientific Basis of Culture Media in Pharmaceutical Microbiology:
Culture media are formulated to provide microorganisms with essential nutrients such as carbon and nitrogen sources, minerals, vitamins, and growth factors, as well as appropriate physical conditions including pH and osmotic balance. In pharmaceutical microbiology, the objective of media formulation is not simply to promote rapid microbial proliferation but to ensure reliable recovery of microorganisms that may be present in low numbers or in a sub-lethally injured state.
Microorganisms present in pharmaceutical products and manufacturing environments are often subjected to multiple stress conditions, including heat, desiccation, sub-inhibitory concentrations of antimicrobial agents such as disinfectants and preservatives, and process-related factors such as variations in temperature, pH, and moisture. In addition, human microflora is a major source of contamination in the pharmaceutical industry. Culture media used in pharmaceutical testing must therefore be capable of effectively resuscitating stressed microorganisms while maintaining the required selectivity and specificity.
3. Regulatory Framework Governing Pharmaceutical Culture Media in the United States:
The use of culture media in pharmaceutical testing within the United States is governed primarily by the United States Pharmacopeia (USP) and by regulations established by the US Food and Drug Administration (FDA). USP General Chapters <61> Microbial Enumeration Tests and <62> Tests for Specified Microorganisms define standardized methodologies for assessing the microbiological quality of non-sterile pharmaceutical products. These chapters specify the recommended culture media, target microorganisms, incubation conditions, and acceptance criteria, thereby providing a standardized framework for media selection and use.
The FDA requires pharmaceutical manufacturers to show that their microbiological test methods work as intended. This includes demonstrating that the culture media used in testing are appropriate, reliable, and capable of producing accurate results for their specific application. During regulatory inspections, FDA investigators routinely assess growth promotion testing, media preparation and storage practices, expiration dating, supplier qualification, and other documentation supporting media suitability. Failure to adequately control culture media has been identified as a recurring source of regulatory observations.
ICH (International Council for Harmonisation) guidelines establish globally harmonized standards for pharmaceutical quality, safety, and efficacy. The US FDA adopts and implements these guidelines within the United States, enabling pharmaceutical companies to align with consistent regulatory expectations and facilitating regulatory approval across multiple regions.
ISO 11133 provides detailed guidance on the preparation, production, storage, and performance testing of culture media. Although ISO 11133 is not a statutory requirement in the United States, however it is widely recognized as a scientific benchmark and is frequently used to support supplier qualification and internal quality system design. Alignment with ISO 11133 principles enhances consistency, traceability, and scientific rigor in pharmaceutical microbiology laboratories.
4. Classification of Culture Media Used in Pharmaceutical Testing:
Culture media are designed to support the growth of a broad spectrum of microorganisms and are primarily used for quantitative microbial enumeration. Media such as Tryptic Soy Agar, Tryptic Soy Broth, Sabouraud Dextrose Agar and Potato Dextrose Agar are routinely employed in total aerobic microbial count and total yeast and mold count testing in accordance with USP <61>. These media provide the baseline assessment of microbial bioburden in pharmaceutical products and manufacturing environments.
Selective and differential media are used for the detection and identification of specific objectionable microorganisms. These media incorporate selective agents that inhibit competing flora and differential indicators that facilitate organism differentiation based on metabolic or biochemical characteristics. Culture media including MacConkey Agar, Mannitol Salt Agar, Cetrimide Agar, XLD Agar, EE Broth Mossel, and VRBG Agar are formulated with selective agents and indicators that allow visual identification of microorganisms based on specific biochemical reactions. These media are essential components of testing for specified microorganisms in accordance with USP <62>.
Enrichment media are utilized to enhance the recovery of microorganisms present in low concentrations or in a stressed physiological state. These media provide favorable growth conditions that allow target organisms to proliferate prior to transfer to selective or differential media. Neutralizing media and diluents are essential for method suitability testing when pharmaceutical products contain preservatives or antimicrobial excipients. Neutralizers must effectively inactivate antimicrobial activity without exerting toxic effects on test microorganisms, and their suitability must be experimentally demonstrated.
Different assay media are specialized culture media used in microbiological assays to determine the potency or concentration of antibiotics and vitamins using specified test microorganisms, as described in USP <81>. Sterility media, on the other hand, are used to detect the presence or absence of viable microorganisms in pharmaceutical products required to be sterile. These media form the core of sterility testing, for which the USP specifies two primary media: Fluid Thioglycollate Medium (FTM) and Soybean Casein Digest Medium (SCDM).
Pharmaceutical laboratories can either prepare culture media in-house from dehydrated formulations in compliance with USP <71>, or use ready-to-use media supplied by qualified and approved manufacturers. The use of ready-to-use media helps minimize preparation-related variability and enhances batch-to-batch consistency, provided that robust quality, performance, and regulatory documentation is available to support their use.
5. Manufacturing and Quality Control Considerations:
The performance of pharmaceutical culture media is directly influenced by the quality of raw materials, manufacturing processes, and quality control systems. Components such as peptones and yeast extracts are derived from biological sources and can exhibit inherent variability if not rigorously controlled. Variations in nutrient composition, buffer capacity, or agar gel strength can affect microbial growth characteristics and test reproducibility. Water quality is critical for pharmaceutical applications, and only purified water with a conductivity of less than 1.3 µS/cm at 25° C as per USP <645> should be used.
Established manufacturers operate controlled manufacturing systems with defined raw material specifications, validated production processes, and comprehensive batch release testing. Each batch of culture media is supported by a Certificate of Analysis documenting physical characteristics, pH, sterility (where applicable), and growth promotion performance using specified reference organisms. In addition, a complete quality control report is provided to support compliance and regulatory requirements.
HiMedia has established itself as a global leader in the manufacture of microbiological culture media through sustained investment in scientific expertise, manufacturing infrastructure, and quality systems. With decades of experience and one of the most extensive culture media portfolios worldwide, HiMedia supports pharmaceutical laboratories by providing consistent, well characterized media that align with pharmacopeial and regulatory expectations.
6. Growth Promotion and Performance Qualification:
Growth promotion testing is a mandatory scientific and regulatory requirement for pharmaceutical culture media. The purpose of growth promotion testing is to verify that the culture media are capable of supporting the growth of the required microorganisms when used under the laboratory’s routine testing conditions. This testing serves as evidence of nutritional adequacy and absence of inhibitory substances.
Growth promotion testing is performed using defined reference strains obtained from recognized culture collections. Acceptance criteria are based on pharmacopeial and ISO guidance and depend on whether the test method is qualitative or quantitative. Even when suppliers provide growth promotion data, pharmaceutical laboratories must independently confirm media performance using their own preparation procedures, incubation conditions, and testing methods.
Growth promotion testing is required for every new lot of prepared media, for each batch of media prepared in house, and whenever there are significant changes to media preparation, storage, or incubation conditions. Accurate and complete documentation of growth promotion results is critical to ensure data integrity and to demonstrate regulatory compliance.
7. Media Preparation, Storage, and Stability Considerations:
The way culture media are prepared and stored has a direct impact on their performance. Media should be prepared following validated procedures, using appropriate quality water and accurate measurement of dehydrated components. The pH must be checked and adjusted when necessary, and sterilization processes should be validated to ensure microorganisms are effectively eliminated without damaging the nutritional components of the media.
Once prepared, media must be handled using aseptic techniques and stored under controlled conditions to avoid contamination, drying, or chemical deterioration. Prepared media should be clearly labeled with the media name, lot number, preparation date, and expiration date to ensure proper traceability and control. All media should be visually inspected prior to use for any signs of contamination or defects, such as cracks, precipitation, or crystal formation. Following recommended storage conditions and shelf life is essential to maintain consistent media performance during use.
8. Method Suitability and Neutralization Studies:
Method suitability testing also know as method validation is performed to confirm that a microbiological test method, including the culture media, can successfully recover microorganisms when the pharmaceutical product is present. This is especially important for products that contain preservatives, alcohol, or other antimicrobial ingredients, as these substances can inhibit microbial growth. Neutralization studies must show that antimicrobial activity is effectively neutralized and that the neutralizing agents do not harm the test microorganisms.
During FDA inspections, method suitability studies are often closely reviewed, and insufficient validation of neutralization is a common regulatory concern. For this reason, well designed and properly documented method suitability studies are a critical part of a compliant pharmaceutical microbiology program.
9. Documentation and Quality System Integration:
In pharmaceutical microbiology laboratories, culture media must be managed as part of the overall quality management system. This requires maintaining complete records covering media receipt, inspection, preparation, growth promotion testing, use, and disposal. Documentation such as certificates of analysis, deviation reports, investigations, and corrective actions must be maintained in a way that ensures full traceability and protects data integrity.
Comprehensive and well-organized documentation demonstrates that culture media are controlled as critical analytical reagents which can help build regulatory confidence in microbiological test results. Integrating media control effectively into the laboratory quality system also plays a key role in maintaining readiness for regulatory inspection
10. HiMedia’s Contribution to Pharmaceutical Microbiology:
HiMedia is globally recognized as a leading manufacturer of microbiological culture media, peptones, and associated products serving pharmaceutical, biotechnology, clinical, and regulatory laboratories worldwide. With a strong scientific foundation in microbiology and decades of manufacturing experience, HiMedia designs and produces culture media that conform to pharmacopeial requirements and are suitable for use in highly regulated pharmaceutical testing environments. Its products are widely used in applications such as microbial limits testing, tests for specified microorganisms, disinfectant testing, sterility testing, environmental monitoring, pharmaceutical water testing and antibiotic/vitamin assays.
HiMedia’s manufacturing philosophy is built on rigorous raw material qualification, well controlled production processes, and comprehensive quality assurance systems to ensure batch to batch consistency and reliable performance. Each batch of culture media is supported by batch specific certificates of analysis and detailed growth promotion data aligned with pharmacopeial and ISO expectations. Backed by an extensive product portfolio and strong technical expertise, HiMedia supports pharmaceutical laboratories in maintaining consistent test performance, meeting regulatory requirements, and generating reliable microbiological data. This commitment is particularly valuable for laboratories operating within the stringent expectations of the United States regulatory framework, where data integrity, traceability, and method suitability are critical.
11. Emerging Developments in Pharmaceutical Culture Media:
While classical culture-based methods continue to serve as the regulatory gold standard in pharmaceutical microbiology, ongoing advancements in culture media formulation and delivery formats are contributing to improved efficiency, consistency, and interpretability of microbiological results. Regulatory agencies continue to recognize traditional culture methods as the reference approach for compliance testing, yet they also allow the adoption of scientifically justified innovations when supported by appropriate validation and equivalence data.
One significant area of development is the use of chromogenic and differential media designed to enhance visual differentiation of target microorganisms through specific enzymatic reactions. HiMedia media can simplify colony identification, reduce the need for additional confirmatory testing, and improve turnaround time, particularly in environmental monitoring programs and in the detection of specified microorganisms. In regulated pharmaceutical applications, chromogenic media are typically used as supplementary or screening tools and must be validated to demonstrate performance comparable to or better than conventional pharmacopeial media.
HiMedia plant-based hydrolysate media, animal component–free media, and chemically defined media are progressively replacing traditional complex media in biopharmaceutical manufacturing, as they minimize raw-material variability, improve process reproducibility, and better align with regulatory expectations.
Another important trend is the increasing adoption of ready-to-use prepared media, including pre poured plates and ready-to-use broths. HiMedia ready to use prepared media helps in reducing variability associated with in house media preparation, minimize operator-related errors, and improve reproducibility across testing sites. For pharmaceutical laboratories operating under strict quality systems, ready to use media also support improved traceability, standardized performance, and streamlined documentation, provided that supplier controls and batch specific quality data meet regulatory expectations.
Media formulations optimized for environmental monitoring are also evolving, with an emphasis on improved recovery of stressed microorganisms and clearer colony morphology under typical cleanroom conditions. Such media are designed to support trending and early detection of contamination in controlled environments, which is critical for maintaining microbiological control in sterile and non-sterile manufacturing areas.
HiMedia actively supports these emerging developments through continuous research, formulation optimization, and expansion of its product portfolio. The company offers a wide range of chromogenic media, ready to use prepared media, and specialized formulations developed to meet the needs of pharmaceutical quality control and environmental monitoring programs. HiMedia’s product development is guided by pharmacopeial standards, ISO guidance, and practical feedback from regulated laboratories, ensuring that innovations are scientifically sound and suitable for use in compliance driven environments.
Any implementation of advanced culture media in regulated pharmaceutical testing requires thorough validation, including growth promotion testing, method suitability studies, and documented equivalence to established methods. HiMedia supports customers throughout this process by providing detailed technical documentation, batch specific certificates of analysis, growth promotion data, and scientific guidance. This collaborative approach enables pharmaceutical laboratories, particularly those operating within the stringent US regulatory framework, to adopt new media technologies with confidence while maintaining full regulatory compliance.
12. Conclusion:
Culture media constitute a fundamental component of pharmaceutical microbiology, directly impacting product quality, patient safety, and regulatory compliance. A robust media management program necessitates the careful selection of appropriate media, procurement from qualified suppliers, consistent performance in growth promotion and method suitability testing, and comprehensive documentation within the laboratory quality system.
By integrating regulatory expertise with scientific and manufacturing proficiency, laboratories can effectively mitigate microbiological risks and ensure reliable, reproducible results. In the context of the evolving pharmaceutical landscape, ongoing innovation in media formulation and testing is critical to address emerging challenges, such as the detection of resistant microorganisms, while optimizing usability, reproducibility, and operational efficiency.
HiMedia’s extensive experience in culture media development, rigorous quality control, and global supply chain support enables pharmaceutical manufacturers to meet stringent regulatory requirements, including those of the US FDA, while maintaining confidence in microbiological testing programs.
Acknowledgement: The authors express their sincere gratitude to Dr. Rahul Warke (Director, Microbiology Department) and Dr. Girish Mahajan (Senior Vice President, Microbiology Department) for their exceptional scientific guidance, critical insights, and continuous support throughout the development of this work. The authors also thank Ms. Vrutti Mistry (Scientific Writer) for her support in drafting the manuscript.
References:
- Sharma A, Sharma N, Luthra G. The Crucial Role of Microbiological Testing in Ensuring Safety and Efficacy of Medical Devices: An Overview. Journal of Pharmaceutical Research International. 2023;35(12):47-55. doi: https://doi.org/10.9734/jpri/2023/v35i127364
- Basu S, Pal A, Desai P. Quality control of culture media in a microbiology laboratory. Indian Journal of Medical Microbiology. 2005;23(3):159. doi: https://doi.org/10.4103/0255-0857.16586
- Marsit NM, Saadawi S, Alennabi K. Challenges of growth-based microbiological methods in sterility assurance of pharmaceutical product manufacturing. Discover Pharmaceutical Sciences. 2025;1(1). doi: https://doi.org/10.1007/s44395-025-00020-6
- Dao H, Lakhani P, Police A, et al. Microbial Stability of Pharmaceutical and Cosmetic Products. AAPS PharmSciTech. 2018;19(1):60-78. doi: https://doi.org/10.1208/s12249-017-0875-1
- https://www.usp.org/sites/default/files/usp/document/harmonization/gen-method/q05a_pf_ira_34_6_2008.pdf
- United States Pharmacopeia (USP). Chapter: Microbiological Examination of Nonsterile Products: Microbial Enumeration Tests.
- European Pharmacopoeia (Ph. Eur.). Chapter 2.6.1: Microbiological Examination of Non-Sterile Products: Microbial Enumeration Tests.
- World Health Organization (WHO). Good Manufacturing Practices for Pharmaceuticals: Main Principles.
- FDA Guidance for Industry. Sterile Drug Products Produced by Aseptic Processing — Current Good Manufacturing Practice.
- PDA Technical Report No. 33. Evaluation, Validation and Implementation of Alternative and Rapid Microbiological Methods.
- EN ISO International Standardization Organization. Microbiology of food, animal feed and water - Preparation, production, storage and performance testing of culture media + Amendment 1 + Amendment 2. EN ISO 11133:2014/Amd1:2018/Amd2:2020. Available from: https://www.iso.org/standard/70354.html
- MERCK. EN ISO 11133 Microbiological Culture Media. ISO. Published 2022. https://www.sigmaaldrich.com/IN/en/technical-documents/technical-article/food-and-beverage-testing-and-manufacturing/microbiological-analysis-for-food-and-beverage/en-iso-11133-water-for-the-preparation-and-performance-testing?srsltid=AfmBOoqx87bc0F1RxeLticuy97dyDOH_Nfzm69aLtNSqqEwEjRx3pp0I